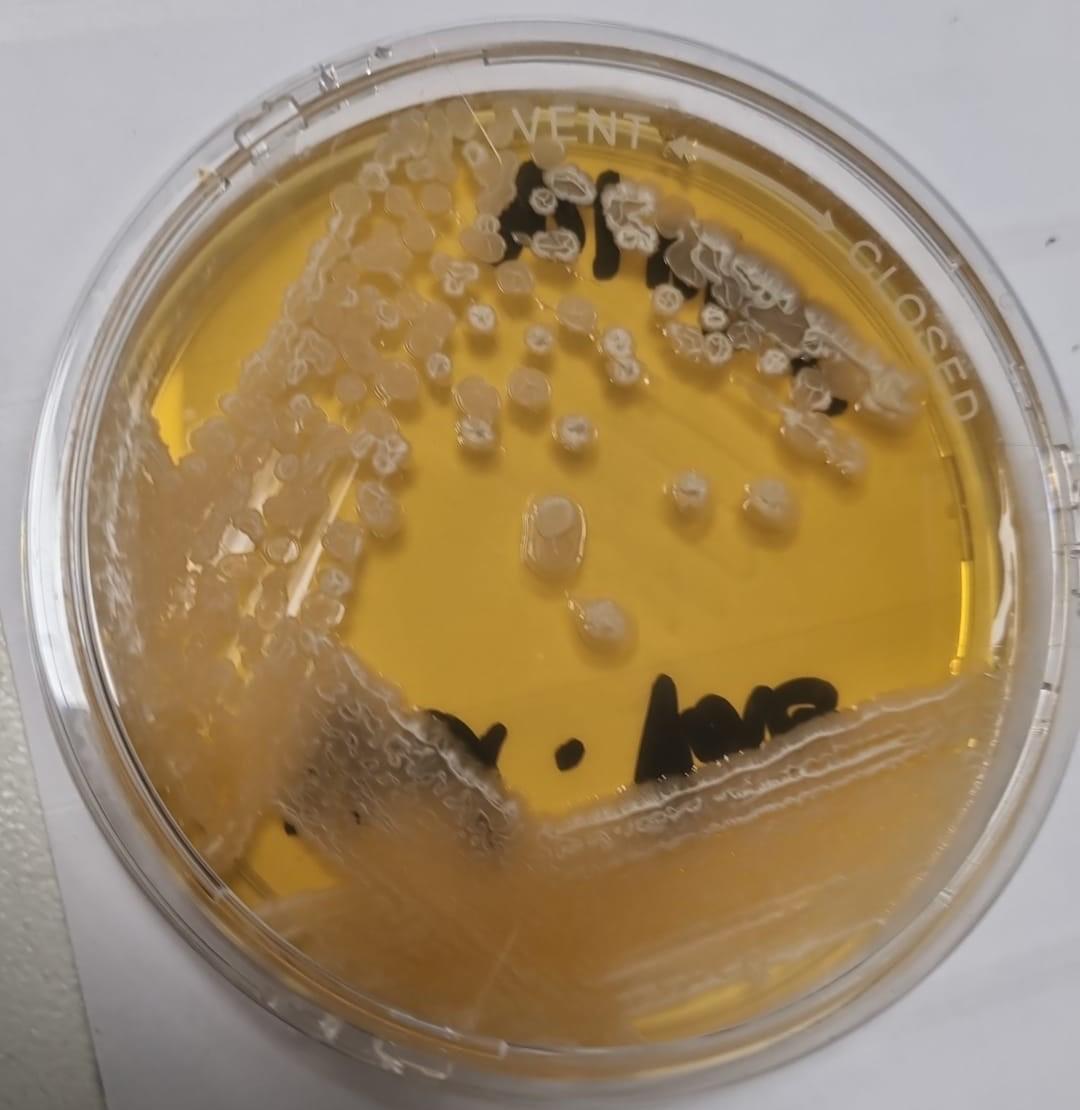
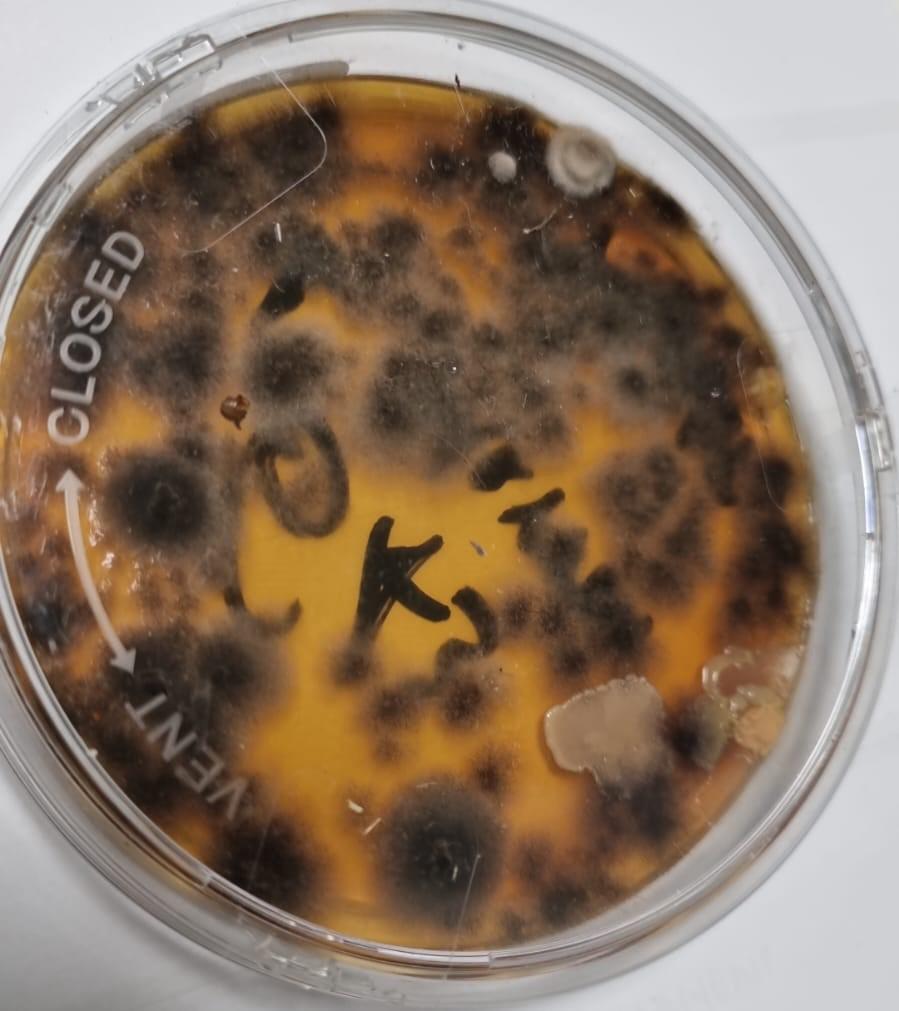

Eficiencia natural, soluciones sostenibles y bienestar integral
En Probionat encontrarás innovación y naturaleza unidas para el crecimiento y mejora de tus cultivos. Trabajamos con el principio de residuo cero y economía circular.
Biotecnología para una agricultura sostenible
Soluciones PROBIONAT basadas en fermentación dirigida, economía circular y respeto al medio ambiente.
En Probionat encontraras innovación y naturaleza unidas para el crecimiento y mejora de tus cultivos. Trabajamos con el principio de residuo cero y economía circular.
Nuestros productos

Nuestros estimulantes ayudan a mejorar las cosechas, incrementando el rendimiento de los cultivos mediante la aportación de metabolitos

Los productos ayudan a activar las defensas naturales contra hongos, bacterias y virus utilizando metabolitos microbianos naturales obtenidos de la fermentación dirigida.

Productos específicos para ayudar a recuperar suelos utilizando extractos obtenidos por fermentación de sustancias naturales y extracciones por medios estrictamente físicos.

Nuestra Empresa
Eficiencia natural, soluciones sostenibles y bienestar integral
En PROBIONAT creemos que la agricultura del presente y del futuro debe ser productiva, pero también responsable. Por eso, desarrollamos productos que aprovechan los procesos naturales de los microorganismos, minimizan el impacto ambiental y favorecen el bienestar global del agroecosistema: suelo, planta y entorno.
Estimulan las defensas naturales de las plantas
Favorecen el equilibrio del ecosistema suelo-planta
Promueven la sostenibilidad
Mejoran la movilidad de los nutrientes y fitohormonas
En PROBIONAT fabricamos productos innovadores utilizando únicamente procesos físicos y biotecnológicos.
Llámanos
Nuestros Servicios

Después de haber analizado el uso de diferentes microrganismos en los cultivos...
Ofrecemos un servicio de aislamiento, selección y multiplicación específica de microorganismos...
Asesoramos mediante el análisis de suelos utilizando técnicas de cromatografía...

En muchas ocasiones los productores buscan fertilizantes mas adaptados...
Lo mejor de trabajar con nosotros
En PROBIONAT unimos biotecnología, experiencia y sostenibilidad para ayudarte a obtener cultivos más sanos, suelos más vivos y producciones rentables.
Biotecnología
Fertilizantes basados en fermentación dirigida.
Equipo técnico
Contamos con más de 30 años de experiencia
Sostenibilidad
Usamos procesos de economía circular
Soluciones a medida
Aplicamos diseños personalizados

Testimonios de nuestros clientes
Llevamos tres campañas utilizando productos de PROBIONAT en nuestras fincas de cítricos ecológicos y la diferencia es muy clara. Las plantas aguantan mejor los picos de calor, hemos reducido notablemente los problemas de hongos en momentos de mayor humedad y, además, hemos podido bajar el uso de otros tratamientos.

Juan Martínez
Buscábamos una alternativa que reforzara las defensas del cultivo sin saturar el programa de fitosanitarios. Con la línea biotecnológica de PROBIONAT hemos conseguido plantas más equilibradas, mejor enraizamiento y una respuesta mucho más rápida frente a situaciones de estrés.

María López
En nuestra explotación combinamos viñedo y olivar y teníamos claro que debíamos avanzar hacia una gestión más sostenible del suelo. Desde que introdujimos los productos de PROBIONAT hemos visto un cambio en la estructura y actividad biológica del terreno, así como una mayor uniformidad en el desarrollo de las plantas.




